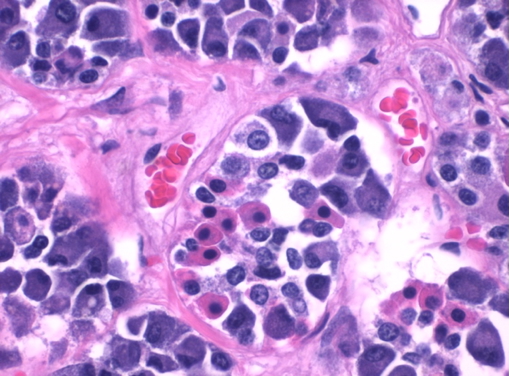
Anterior Pituitary Histology

Table of Contents
Overview – Pituitary Gland
The pituitary gland, often called the “master gland,” plays a vital role in regulating numerous physiological processes by secreting multiple hormones under the control of the hypothalamus. Understanding the pituitary gland’s anatomy, embryology, and hormone regulation is essential for diagnosing endocrine disorders and managing patient care in clinical practice.
Location
- The pituitary gland is located:
- Just anterior to the pons.
- Posterior to the optic chiasma.
- Inferior to the hypothalamus.
- Connected superiorly to the hypothalamus via the infundibulum.
- It secretes at least 9 hormones under hypothalamic control through releasing and inhibiting hormones.
Embryology of the Pituitary Gland
- The anterior and posterior pituitary have distinct embryological origins:
- Anterior Pituitary (Adenohypophysis):
- Derived from an upward out-pouching of oral ectoderm (Rathke’s pouch).
- Composed of glandular epithelial tissue.
- Manufactures and secretes hormones.
- Posterior Pituitary (Neurohypophysis):
- Derived from downward extension of neuroectoderm from the diencephalon.
- Composed of neural tissue.
- Stores and releases neurohormones produced by the hypothalamus.
- Anterior Pituitary (Adenohypophysis):

Anterior Pituitary (Adenohypophysis)
Hormones Produced
- Thyroid Stimulating Hormone (TSH)
- Follicle Stimulating Hormone (FSH)
- Luteinizing Hormone (LH)
- Prolactin (PRL)
- Adrenocorticotropic Hormone (ACTH)
- Growth Hormone (GH)
Secretory Cell Types
| Cell Type | Hormones Secreted |
|---|---|
| Gonadotrophs | FSH, LH |
| Corticotrophs | ACTH |
| Thyrotrophs | TSH |
| Mammotrophs (Lactotrophs) | Prolactin |
| Somatotrophs | GH |
Histology
- Glandular structure with clusters of acini surrounded by portal blood vessels.
- Acini composed of:
- Acidophils (red)
- Basophils (dark blue)
- Chromophobes (colourless)
- Highly vascularised via portal vessels carrying hypothalamic hormones.
Blood Supply
- Arterial: Hypophyseal branches of internal carotid arteries.
- Venous: Venules drain into dural sinuses.

Posterior Pituitary (Neurohypophysis)
- Composed of nervous tissue; extension of the hypothalamus.
- Hormones are synthesised in the hypothalamus (supraoptic & paraventricular nuclei) and transported to the posterior pituitary for storage and release.
Hormones Stored and Released
- Antidiuretic Hormone (ADH)
- Oxytocin
Histology
- Neural origin: resembles brain tissue.
- Contains axons (no neuronal cell bodies), astrocytes, oligodendrocytes, and blood vessels (portal system).


2. OpenStax College, CC BY 3.0 <https://creativecommons.org/licenses/by/3.0>, via Wikimedia Commons
Pituitary Hormones


ACTH (Adrenocorticotropic Hormone)
- Secreted by: Corticotrophs (Anterior Pituitary)
- Function: Stimulates adrenal cortex (zona fasciculata) to produce glucocorticoids.
- Increases blood glucose.
- Enhances lipolysis and proteolysis.
- Reduces inflammation.
- Stimulated by: CRH from hypothalamus (triggered by stress, low glucose, low glucocorticoids, sympathetic activation, diurnal rhythm).
- Regulated by: Negative feedback via hypothalamus-pituitary-adrenal axis.

GH (Growth Hormone)
- Secreted by: Somatotrophs (Anterior Pituitary)
- Functions:
- Increases lean body mass (↑ muscle, ↓ fat).
- Stimulates protein synthesis, bone growth (osteoblast activity), and cell division.
- Anti-insulin effects: gluconeogenesis, glycogenolysis, insulin resistance, lipolysis.
- Indirect effects via IGFs (somatomedins): linear bone growth, tissue growth.
- Stimulated by: GHRH (hypothalamus), ghrelin (stomach), diurnal rhythm.
- Regulated by: Negative feedback loop with hypothalamus and IGFs.

TSH (Thyroid Stimulating Hormone)
- Secreted by: Thyrotrophs (Anterior Pituitary)
- Function: Stimulates thyroid gland growth, hormone synthesis, and release.
- Stimulated by: TRH (hypothalamus), triggered by low T3/T4, cold exposure, low metabolism.
- Regulated by: Negative feedback via hypothalamus-pituitary-thyroid axis.

FSH & LH (Gonadotropins)
- Secreted by: Gonadotrophs (Anterior Pituitary)
- Function:
- Sexual development at puberty.
- Gamete production:
- Males: LH → Leydig cells → testosterone; FSH → Sertoli cells → sperm production.
- Females: LH → ovulation, progesterone/oestrogen; FSH → follicle development.
- Stimulated by: GnRH (hypothalamus).
- Regulated by: Negative feedback via hypothalamus-pituitary-gonadal axis.

PRL (Prolactin)
- Secreted by: Lactotrophs (Anterior Pituitary)
- Function: Promotes breast tissue growth during pregnancy and milk production postpartum.
- Stimulated by: PRH; also influenced by suckling.
- Regulated by: Dopamine (PIH) inhibition, suckling stimuli, and sex hormones.

ADH (Antidiuretic Hormone / Vasopressin)
- Secreted by: Posterior Pituitary
- Function:
- Regulates blood pressure and volume.
- V1 receptors: vasoconstriction (↑ systemic vascular resistance).
- V2 receptors: water reabsorption in renal collecting ducts.
- Stimulated by: Low blood volume, increased plasma osmolality, angiotensin II.
- Regulated by: Plasma osmolality, total body water, renin-angiotensin system.

Oxytocin
- Secreted by: Posterior Pituitary
- Function:
- Stimulates uterine contractions during labour.
- Facilitates milk let-down during breastfeeding.
- Stimulated by: Cervical stretch, suckling.
- Regulated by: Positive feedback mechanisms (labour and breastfeeding).


2. OpenStax College, CC BY 3.0 <https://creativecommons.org/licenses/by/3.0>, via Wikimedia Commons
Summary – Pituitary Gland
The pituitary gland regulates multiple endocrine pathways through its anterior and posterior components, integrating hypothalamic signals to maintain physiological balance. A clear understanding of pituitary gland structure, function, and hormonal regulation is essential for clinical endocrinology. For a broader context, see our Endocrine Overview page.